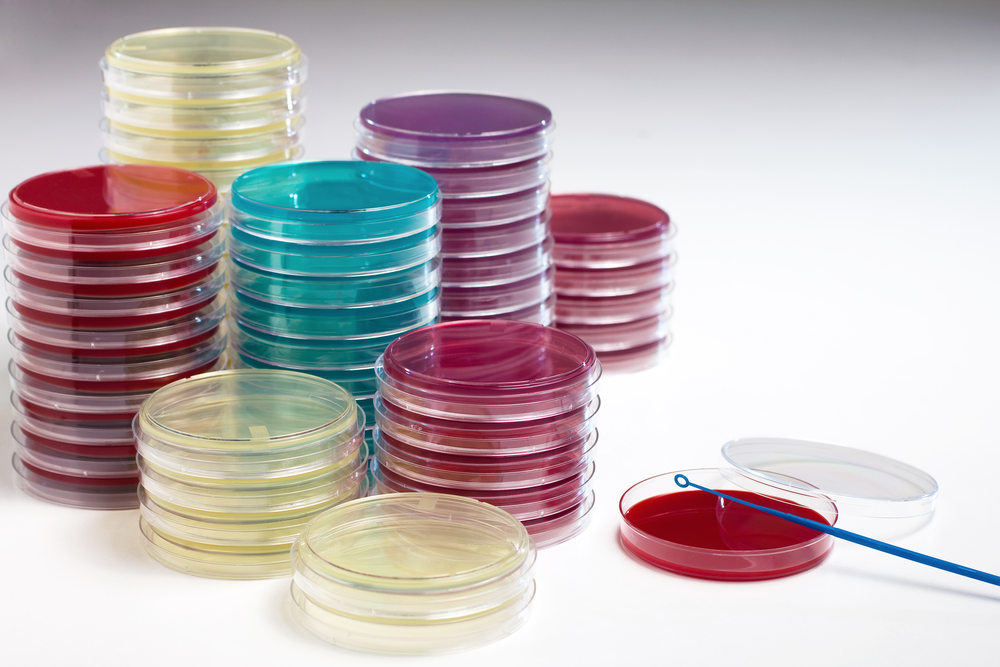

Анализы мочи – рутинные исследования, и при обращении к педиатру по любому поводу (включая профилактический осмотр или осмотр для получения справки в бассейн, музыкальную, спортивную школу и т. д.) в обязательном порядке назначается хотя бы общий анализ мочи. Если же в анализе обнаруживаются изменения, назначаются дополнительные исследования. Но что именно обозначают результаты анализов мочи, какова их норма и о чем говорят отклонения?
Мы уже писали о том, как правильно собрать у ребенка мочу на анализ. Теперь расскажем о трактовке анализов мочи у детей.
Общий анализ мочи

В приведенной ниже таблице вы можете увидеть нормальные показатели общего анализа мочи у ребенка.
| Показатель | Аббревиатура на бланке с электронного анализатора | Нормальные интервалы |
| Цвет | Color | От светло-желтого (соломенно-желтого, с/ж) до желтого |
| Прозрачность | Clarity | Прозрачная |
| Объем | V | Значения не имеет (сколько сдали) |
| Удельный вес | SG | до 2 лет: 1012-10222-3 года: 1010-1017
старше 5 лет: 1012-1025 подростки: 1010-1040 |
| Глюкоза | GLU | Отрицательный/Negative |
| Билирубин | BIL | Отрицательный/Negative |
| Ацетон | KET | Отрицательный/Negative |
| кислотно-щелочная реакция | pH | 4.5-8.0 |
| Белок | PRO | Отрицательный/Negative |
| Уробилиноген | UBG | До 17 мкмоль/л (umo/L) |
| Лейкоциты | LEU | У мальчиков: 0-1-2 в ПЗ/ NegativeУ девочек: 0-2 и до 8-10 в ПЗ/ Negative |
| Эритроциты | BLD | 0-1/ Negative |
| Цилиндры | Обычно приписывают от руки (цил.) | Нет |
| Эпителий | (Эп. или эп. кл.) | Единичный, до 10 в ПЗ |
| Соли | (название солей приписывают от руки – фосфаты и др.) | Нет |
| Слизь | Нет | |
| Бактерии | NIT | Нет |
Отклонения от нормы и их значение
Изменения цвета:
- Темно-желтый цвет (гиперхромурия) – концентрированная моча. Физиологическая гиперхромурия отмечается в летнее время и вообще при усиленном потоотделении, на фоне употребления небольшого количества жидкости. Также возможно темное окрашивание мочи при употреблении моркови. Патологическая гиперхромурия возникает при обезвоживании (поносы, лихорадка, рвота) и голодании (в том числе при нехватке грудного молока), при заболевании печени, сердца.
- Очень бледная, бесцветная моча (гипохромурия) – отмечается на фоне обильного питья и употребления продуктов с мочегонным эффектом. Патологическая гипохромурия возникает при сахарном и несахарном диабете, нефросклерозе и некоторых других заболеваниях почек.
- Оранжевый цвет – при употреблении пищи, богатой бета-каротином (морковь, хурма, абрикосы и другие яркоокрашенные оранжевые и желто-оранжевые фрукты и овощи); на фоне приема рибофлавина, поливитаминов и витамина C.
- Розовый и красный цвет мочи – чаще всего свидетельствует о наличии в моче крови (циститы, гломерулонефриты, мочекаменная болезнь). Кроме того, красная моча бывает при тяжелых токсикозах, наследственной порфиринурии, приеме некоторых лекарств (сульфазол, красный стрептоцид, амидопирин).
- Коричневый цвет обусловлен наличием в моче билирубина и желчных пигментов (уробилиноген, уробилиноиды, стеркобилиноген) или расщепленных эритроцитов. Отмечается при болезнях печени, механической желтухе (когда желчь не может поступить из желчного пузыря в кишечник), гемолитических анемиях.
- Молочно-белый цвет – при наличии в моче жиров (сахарный диабет) или лимфы (туберкулез и опухоли органов мочевыделительной системы).
- Зеленый, синий цвет – при тяжелой желтухе, приеме метиленовой сини.
- Бурый и черно-бурый цвет – при меланозе (избыточное накопление меланина), алкаптонурии (наследственное заболевание обмена веществ), отравлении нафтолом.
Изменения прозрачности
Мутная моча отмечается при высоком содержании в ней лейкоцитов, слизи (воспалительный процесс почек или органов мочевыделения). При наличии солей моча становится мутной не сразу, а после отстаивания.
Удельный вес
Удельный вес будет повышен при выделении концентрированной мочи (обезвоживание, лихорадка, ограниченный прием жидкости) и понижен при выделении разбавленной мочи (обильное питье, диабет, полиурия при поражении почек).
Глюкоза
Сахар в моче (глюкозурия) обнаруживается в случае употребления накануне сдачи анализа большого количества рафинированных углеводов; у недоношенных детей – из-за незрелости почечных канальцев. Глюкозурия может быть следствием гипергликемии (повышения уровня глюкозы крови) на фоне сахарного диабета, наследственных нарушений метаболизма сахаров (галактоземия). Кроме того, глюкозурия возможна при нормальном уровне глюкозы крови, например, отмечается при ряде почечных заболеваний, сопровождающихся нарушением функции канальцев почек (синдром Фанкони).
Ацетон (кетоновые тела)

Кетонурия (кетоновые тела в моче – ацетон, ацетоуксусная и бета-оксимасляная кислоты) отмечается при выраженных нарушениях углеводного, жирового и белкового обмена. У детей углеводный обмен легко нарушается, поэтому кетоны обнаруживаются достаточно часто:
- при голодании (у новорожденных – при недокорме);
- при несбалансированном питании (у детей со склонностью к ацетонемическим кризам к ацетонурии могут приводить даже небольшие погрешности в диете, особенно на фоне инфекционных заболеваний);
- при отравлениях;
- на фоне лихорадки;
- при острых инфекциях (ОРВИ, грипп, скарлатина и т. д.);
- у детей с нервно-артритическим диатезом – на фоне стресса (даже в случае положительных эмоций), нервного перевозбуждения, переутомления.
Изменения кислотно-щелочной реакции
Реакция мочи очень сильно зависит от питания: чем больше белка, тем ниже pH. Кислая моча (pH<4) может свидетельствовать о рахите в период разгара, отмечается при сахарном диабете, лихорадке и некоторых других состояниях. Щелочная реакция с pH>8 часто отмечается при инфекции мочевой системы, отравлениях солями тяжелых металлов, сульфаниламидами. Если реакция мочи всегда щелочная, необходимо исключить тубулярные нарушения (почечный ацидоз).
Белок
Появление белка в моче называется протеинурия. Однократные невысокие количества белка могут обнаруживаться у практически здоровых детей после физической нагрузки или при лихорадке на фоне острого инфекционного заболевания. Но даже единичное обнаружение следов белка требует повторения анализа или дообследования для исключения почечной патологии. Постоянная протеинурия отмечается при заболеваниях почек: от следовых количеств белка на фоне пиелонефрита до массивной протеинурии при нефротическом синдроме.
Билирубин и желчные пигменты
Появление в моче билирубина и повышенное содержание уробилиногена отмечается при болезнях печени и гемолитической желтухе. При физиологической желтухе новорожденных концентрация уробилиногена в моче возрастает незначительно. Полное отсутствие уробилиногена бывает у детей раннего возраста (до 3-6 месяцев), а позже свидетельствует о механическом препятствии выходу желчи в кишечник (механическая желтуха).
Лейкоциты
Повышенное содержание лейкоцитов характеризует инфекцию почек или органов мочевыделения и обнаруживается при цистите, уретрите, пиелонефрите, туберкулезе почек, абсцессе почек.
Пограничные значения лейкоцитов у девочек (от 4-5 и до 10) часто бывают при погрешностях при сборе анализов (не был проведен туалет наружных половых органов, или моча была собрана с первой порции).
Следует принимать во внимание, что у девочек лейкоциты в мочу могут попадать не только из мочевыводящих путей, но и из влагалища при кольпитах и других воспалительных гинекологических заболеваниях; а у мальчиков – при баланопоститах, фимозе.
Эритроциты
Повышение количества эритроцитов – кровь в моче или гематурия. Когда эритроцитов очень много, они изменяют цвет мочи (цвет мясных помоев, розовый, красный), и тогда говорят о макрогематурии. Единичные эритроциты на глаз не видны и определяются только микроскопически (микрогематурия).
Гематурия появляется при различных заболеваниях почек:
- гломерулонефриты, интерстициальные нефриты, пиелонефриты;
- опухоли почек и мочевого пузыря;
- мочекаменная болезнь;
- геморрагический цистит;
- уретрит;
- травма органов мочевыделения;
- туберкулез почек.
Единичные эритроциты, до 5-10 в поле зрения, часто наблюдаются при дизметаболической нефропатии. Гематурия возникает также при заболеваниях системы крови у детей (геморрагические диатезы), при геморрагической лихорадке с почечным синдромом.
При трактовке результатов анализов мочи девочек-подростков необходимо узнавать, не был ли сдан анализ на фоне менструации, когда кровь могла попасть в мочу из влагалища.
Цилиндры
С мочой выделяются несколько видов цилиндров: гиалиновые, эритроцитарные и лейкоцитарные, эпителиальные, зернистые, жировые и восковидные.
- Гиалиновые могут встречаться у здоровых детей при физической нагрузке, обезвоживании.
- Эритроцитарные цилиндры свидетельствуют о наличии гломерулонефрита, но отмечаются также при инфаркте и травме почек.
- Лейкоцитарные цилиндры в сочетании с другими признаками инфекции мочевыводящих путей говорят о пиелонефрите.
- Эпителиальные цилиндры находят при поражении почечных канальцев.
- Зернистые и жировые цилиндры выделяются при нефротическом синдроме.
- Восковидные обнаруживаются при почечной недостаточности.
Эпителий
В моче ребенка может обнаруживаться несколько типов эпителия: плоский, переходный и почечный. Плоский и переходный эпителий в небольшом количестве присутствует почти всегда, его количество возрастает при воспалении мочевых путей или при повреждении их слизистой оболочки твердыми кристалликами солей. Почечный эпителий, если он изредка обнаруживается в моче в единичном количестве, при прочих нормальных показателях тоже считается вариантом нормы, но если одновременно с почечным эпителием обнаруживают белок, цилиндры или лейкоциты с эритроцитами, то это подтверждает диагноз заболевания почек.
Соли
В норме солей в моче быть не должно, но они могут иногда появляться после употребления в пищу определенных продуктов (мочевая кислота – при избытке мясной пищи в рационе ребенка, оксалаты – после употребления какао, шоколада и др.). Если соли встречаются в анализах мочи периодически, то это делает вероятным диагноз дизметаболической нефропатии. Постоянное обнаружение большого количества солей требует подробного обследования ребенка (для исключения мочекаменной болезни и другой патологии почек). При инфекциях почек и мочевыводящих путей в моче нередко присутствуют трипельфосфаты и аморфные фосфаты.
Слизь
Слизь в сочетании с эпителиальными клетками говорит о повреждении слизистой оболочки мочевых путей воспалительным процессом либо кристаллами солей.
Бактерии
Моча, собранная при обычном мочеиспускании, не является стерильной. Но число бактерий в ней невысоко и при обычном исследовании они не определяются. Если же в результатах указано наличие бактерий (от + до ++++), рекомендуется продолжить обследование ребенка с проведением анализа мочи на стерильность.
Накопительные пробы
В случае сомнительных результатов анализов мочи (следы белка, пограничные значения лейкоцитурии и др.) и подозрении на заболевание почек или мочевыводящих путей, а также для планового обследования детей с уже имеющимися болезнями почек и органов мочевыделения используют накопительные пробы. К накопительным пробам относятся пробы Аддиса-Каковского, Амбурже и Нечипоренко. Они позволяют обнаружить лейкоциты и эритроциты в моче, даже если они присутствуют не всегда, а только периодически в течение дня.
Нормы накопительных проб мочи у детей
| Проба | Лейкоциты | Эритроциты |
| По Аддису-Каковскому | До 2 млн | До 1 млн |
| По Амбурже | До 2 тыс. в минуту или до 120 тыс. в час | До 750 в минуту или до 45 тыс. в час |
| По Нечипоренко | До 2 тыс. (по некоторым авторам – до 4 тыс.) | До 1 тыс. |
Превышение нормальных значений свидетельствует о заболеваниях почек или органов мочевыделения.
Проба Зимницкого
Анализ мочи по Зимницкому назначается для оценки функции почек. По нему исследуют только 3 показателя: удельный вес мочи и его колебания в течение суток, суточный диурез (количество мочи за сутки) и соотношение между ночным и дневным диурезом.
Нормы исследования по Зимницкому для детей
| Показатель | Нормальные значения |
| Удельный вес | В течение суток разница между максимальным и минимальным удельным весом должна составлять не менее 8 (например, 1022 – 1009 = 13 – норма) |
| Суточный диурез | Дети 5-10 лет: 700-1200 мл в суткиДети 10-14 лет: 1000-1500 мл в сутки
Старше 14 лет: 1000-2000 мл в сутки |
| Соотношение дневного и ночного диуреза | От 4:1 до 3:1 |
Отклонения от нормы:
Гипоизостенурия – уменьшение разницы между максимальным и минимальным удельным весом (размах равен или меньше 7 единиц) – говорит о снижении концентрационной способности почек. Отмечается при остром и хроническом пиелонефрите, почечной недостаточности.
Увеличение суточного количества мочи (полиурия) возможно на фоне начальной стадии почечной недостаточности, а также при внепочечных заболеваниях (сахарный и несахарный диабет и др.), на фоне обильного употребления жидкости.
Уменьшение суточного количества мочи отмечается при поздних стадиях почечной недостаточности, при гломерулонефрите, ГЛПС, нефротическом синдроме, заболеваниях сердца и др.
Стирание разницы между дневным и ночным диурезом возникает при начальной степени почечной недостаточности, а при выраженном нарушении функции почек ночной диурез преобладает над дневным (никтурия).
Трехстаканная и двухстаканная пробы
Эти пробы используются для ориентировочного определения локализации воспалительного процесса или источника крови в моче. Количество форменных элементов (эритроцитов и лейкоцитов) в норме в каждой порции должно быть таким же, как и в общем анализе мочи. При трехстаканной пробе повышение уровня клеток в первой порции свидетельствует о локализации болезненного процесса в наружных половых органах или начальном участке уретры; если показатели повышены во второй порции – предполагается поражение уретры; при изменениях в третьей порции вероятны воспаления мочевого пузыря. Когда патологические изменения находят сразу в трех порциях, то это может свидетельствовать о заболеваниях почек, мочеточников, мочевого пузыря.
Изменения в 1-й порции двухстаканной пробы также подтверждают локализацию воспаления в половых путях; преимущественные изменения во 2-й порции свидетельствуют о патологии уретры. Одинаково выраженные патологические изменения в обеих порциях наблюдаются при заболеваниях почек и (или) мочевого пузыря.
Посев мочи на стерильность (бактериологическое исследование)
Нормальный результат – количество микроорганизмов ниже 1,0 × 102 КОЕ в 1 мл мочи, взятой при обычном мочеиспускании из средней порции. Сомнительным считается результат от 103 до 10 4 КОЕ в 1 мл. Наличие бактерий в моче (бактериурия) подтверждается при значениях 10 5 КОЕ в 1 мл и выше. Бактериурия отмечается при различных инфекционно-воспалительных заболеваниях почек и мочевыводящих путей.
Биохимический анализ мочи
Биохимическое исследование мочи у детей чаще всего назначают для исследования суточного выведения солей и кальция с мочой.
Нормативы
| Показатель | Норма за сутки |
| Мочевая кислота | 0,09-0,12 ммоль/кг веса |
| Оксалаты | 5 ммоль/кг |
| Фосфаты | 1-2 года – 0.2 г3-10 лет – 1.5-3.0 г
Старше 10 лет – 3 г |
| Кальций | 0.1 ммоль/кг |
Повышение показателей подтверждает дизметаболические нарушения. Изолированное увеличение уровня мочевой кислоты характерно для детей с нервно-артритическим диатезом.
Заключение
В заключение хотелось бы напомнить, что заниматься самодиагностикой ни в коем случае недопустимо! Представленная информация может потребоваться родителям для получения дополнительных сведений о причинах изменений в анализах, а также послужить стимулом для обращения за дообследованием. Но проводить трактовку результатов исследований, а тем более ставить диагноз и назначать лечение должен только врач!
К какому врачу обратиться
Разъяснить результаты анализа мочи может врач, направивший ребенка на обследование, чаще всего это педиатр. Если в анализе обнаружены отклонения, ребенка после дообследования могут направить на консультацию к соответствующему специалисту: урологу, нефрологу, эндокринологу, инфекционисту, кардиологу, гастроэнтерологу.
